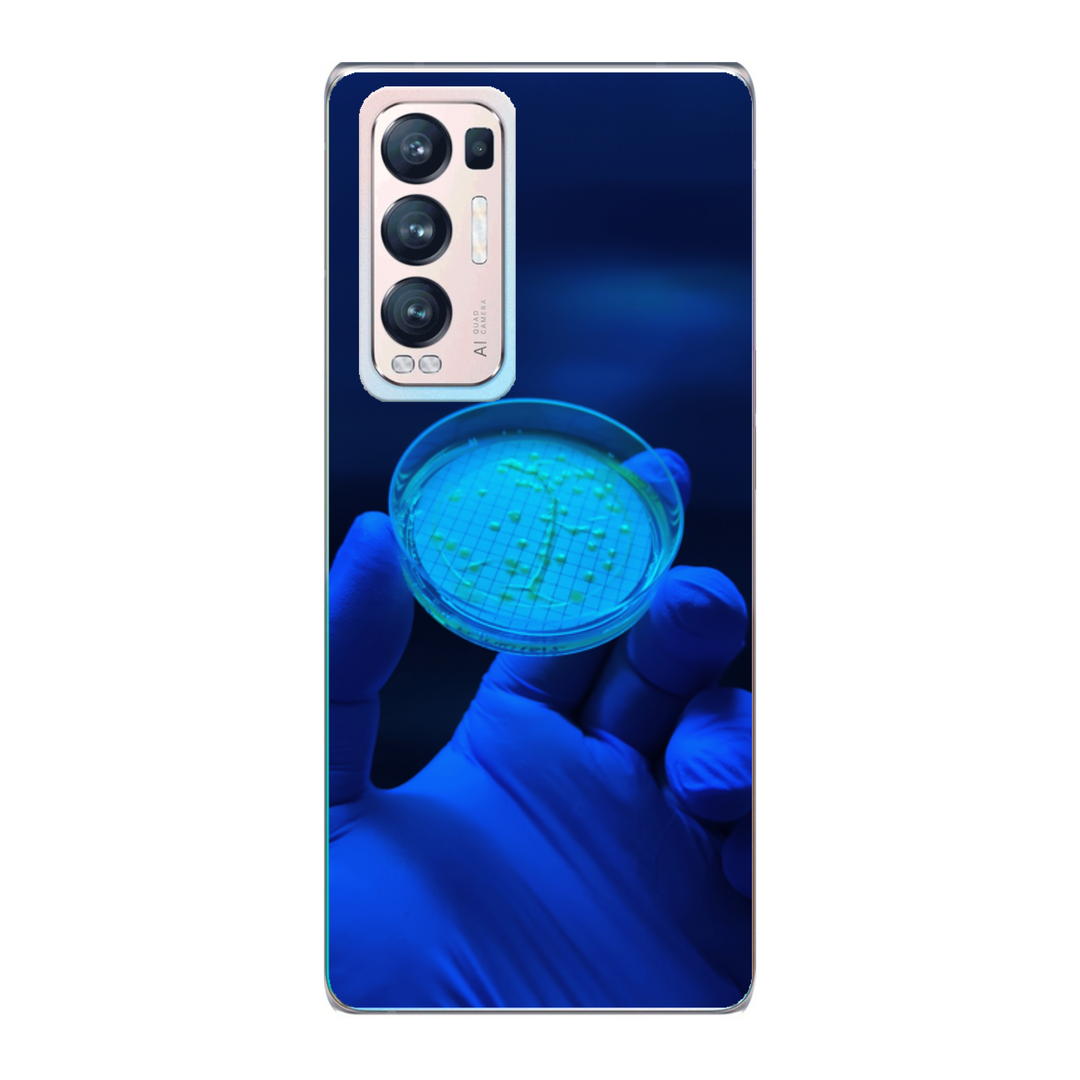

-
Cover Personalizzate
-
Prodotti
-
Collezioni
-
Accessori
Spedizioni gratuiteper ordini superiori a 70€

Sconti fino al 50%
È arrivato il Black Friday che aspettavi!
Sconti mozzafiato fino al 50% su una selezione imperdibile!
Non lasciare che le offerte migliori ti sfuggano!

Cerca tra 400 modelli
Utilizza il nostro potentissimo motore di ricerca e trova velocemente il tuo smartphone! Crea la tua cover personalizzata con le foto e i testi che preferisci!